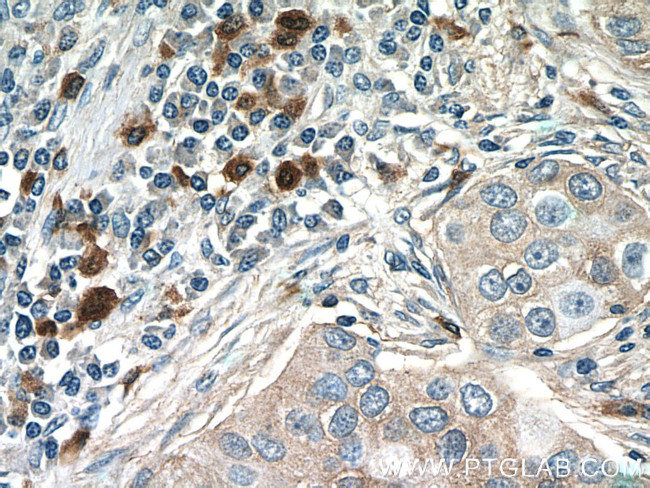
CXCL17 Antibody in Immunohistochemistry (Paraffin) (IHC (P))

Search
Proteintech
CXCL17 Polyclonal Antibody
{{$productOrderCtrl.translations['antibody.pdp.commerceCard.promotion.promotions']}}
{{$productOrderCtrl.translations['antibody.pdp.commerceCard.promotion.viewpromo']}}
{{$productOrderCtrl.translations['antibody.pdp.commerceCard.promotion.promocode']}}: {{promo.promoCode}} {{promo.promoTitle}} {{promo.promoDescription}}. {{$productOrderCtrl.translations['antibody.pdp.commerceCard.promotion.learnmore']}}
产品信息
18108-1-AP
种属反应
宿主/亚型
分类
类型
抗原
偶联物
形式
浓度
规格
纯化类型
保存液
内含物
保存条件
运输条件
产品详细信息
Immunogen sequence: SLNPGVARG HRDRGQASRR WLQEGGQECE CKDWFLRAPR RKFMTVSGLP KKQCPCDHFK GNVKKTRHQR HHRKPNKHSR ACQQFLKQCQ LRSFALPL (23-119 aa encoded by BC093946 )
靶标信息
CXCL17 is a chemokine that acts as chemoattractant for monocytes, macrophages and dendritic cells. In particular, CXCL17 is a mucosal chemokine that attracts dendritic cells and blood monocytes to the lungs. CXCL17 plays a role in angiogenesis and possibly in the development of tumors. Further, CXCL17 acts as an anti-inflammatory in the stomach and may play a role in the innate defense against infections. CXCL17 also activates the C-X-C chemokine receptor GPR35 to induce a rapid and transient rise in the level of intracellular calcium ions. 4-Cys CXCL17 seems to exhibit much higher chemoattractant potency on monocytes and macrophages than 6-Cys CXCL17. Diseases associated with CXCL17 dysfunction include cholera.
仅用于科研。不用于诊断过程。未经明确授权不得转售。
生物信息学
蛋白别名: 6-Cys CXCL17; C Cmotif chemokine; C X C motif chemokine; C-X-C motif chemokine 17; CC motif chemokine; CCmotif chemokine; chemokine (C-X-C motif) ligand 17; CXC; CXC motif chemokine; CXCL; Dendritic cell and monocyte chemokine-like protein; DMC; unnamed protein product; VCC-1; VEGF co-regulated chemokine 1; VEGF coregulated chemokine 1
基因别名: CXCL17; Dcip1; DMC; UNQ473; UNQ473/PRO842; VCC-1; VCC1
UniProt ID: (Human) Q6UXB2
Entrez Gene ID: (Human) 284340